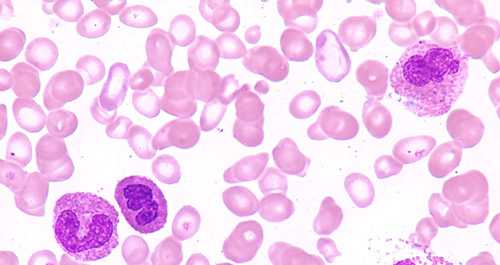

Эозинофилы повышены у взрослого – о чем это говорит и что надо делать (таблица нормы)
Норма эозинофилов состоит в пределах 1-5% в общей лейкоцитарной формуле, она одинакова для мужчин и женщин. Допускается количественный подсчет, тогда нормы колеблются в пределах 120-350 единиц эозинофилов на 1 миллилитр крови. Определяют уровень эозинофилов методом лазерной проточной цитометрии.
Правила забора крови на проверку содержания эозинофилов
Непосредственно влияют на их содержание в крови состояние надпочечников, менструальный цикл. Из-за этих факторов у взрослого могут быть повышены эозинофилы. О чем это говорит и что надо делать – расскажет на приеме терапевт. При необходимости он направляет пациента на консультацию эндокринолога, гематолога.

Для получения достоверного результата к сдаче анализа надо готовиться:
- лаборанты берут капиллярную кровь утром, пока пациент ничего не ел;
- за 2 дня до анализа не рекомендуется есть сладости, пить спиртное;
- за 2 дня нельзя есть цитрусовые;
- за сутки прекратить прием лекарственных препаратов;
- сдавать кровь в нормальном эмоциональном состоянии, без тревоги и волнений.
Правила несложные, их могут соблюсти все пациенты, которым необходимо узнать максимально точное число эозинофилов.

Если у взрослого повышены эозинофилы, о чем это говорит? Об отклонении от нормы. Если насчитывается более 700 эозинофилов в 1 мл крови (в бланке анализа это указано как 7*10 в 9 степени г/л), то это считается очень высоким превышением нормальных показателей.
На что указывает увеличение показателей эозинофилов
При стойко высоком содержании Э-клеток медики классифицируют это состояние как эозинофилия. В МКБ-10 она скрыта под шифром D72.1, включающим аллергическое, наследственное заболевание.
Различаются следующие степени эозинофилии:
- слабая, при повышении показателей на 10%;
- средняя, со скачком показателей на 10-15%;
- тяжелая, при увеличении уровня более чем на 15%.

Серьезное повышение нормы эозинофилов у взрослого говорит от том, что ткани и клетки ощущают дефицит кислорода, органы перестают выполнять свои функции. Кода результат исследования крови показывает значительное превышение Э-клеток у взрослого человека, проводят повторный анализ, после чего в индивидуальном порядке назначают диагностику:
- общий анализ мочи;
- общий анализ кала;
- исследование кала на наличие гельминтов;
- УЗИ внутренних органов;
- проверку аллергопроб.
Точное содержание дополнительных исследований врач определяет исходя из жалоб пациента, своих подозрений на наличие скрытых заболеваний. Знаки АБС Э-клеток указывают на возможность их подсчета особым путем: число всех лейкоцитов умножают на процентное содержание эозинофилов.
Повышение эозинофилов АБС у взрослого говорит о наличии аллергии разной этиологии:

Повышается концентрация Э-клеток при онкологических болезнях крови, при поражениях органов пищеварения, что проявляется гастритами, колитами. Развитие на тканях внутренних органов злокачественных новообразований также приводит к высоким показателям эозинофилов.
При подтверждении своих подозрений терапевт направляет пациента на консультацию к аллергологу, который по своему усмотрению может назначить дополнительное обследование:
- для подтверждения аллергического насморка берут мазки из зева и носа;
- для подтверждения астмы проводят провокационные пробы, спирометрию;
- в любой ситуации определяют аллергены в сыворотке крови.

При поражении легких, подтвержденных рентгеновскими снимками, пациенту назначают консультацию пульмонолога. Если обнаружена глистная инвазия, потребуется консультация инфекциониста, паразитолога. Только после наиболее полного обследования по его результатам врачи коллегиально назначают лечение выявленного заболевания.
Лечение повышенных эозинофилов у взрослого говорит о выборе направления на исцеление от основного заболевания, потому что сами Э-клетки медицинской коррекции не поддаются. Их число можно понизить, только вылечив выявленную патологию.

В ходе лечения проводятся контрольные анализы для проверки правильного выбора медикаментов, нормального течения терапии. Все получаемые данные врачи сверяют с нормами, указанными в таблицах.
Таблица нормы эозинофилов у взрослых людей
Возраст человека
Норма эозинофилов
Процентное отношение от общего числа лейкоцитов
Абсолютный показатель
В лейкоцитарной формуле
До 5 %
0,02 – 0,5 *10^9/л
В риноцитограмме
До 7 %
Не высчитывается
От 15 до 20 лет
От 1% до 5%
0-0,45 – x10⁹/литр
После 21 года
От 1% до 5%
0-0,47 – x10⁹/литр
Таблица содержания эозинофилов в общей лейкограмме у взрослых
Группа клеток
Доля, %
Абсолютный показатель, 10⁹/л
Палочкоядерные нейтрофилы
1‒6
0,04‒0,3
Сегментоядерные
48‒75
2,0‒5,5
Эозинофилы
0,5‒5
0,02‒0,3
Базофилы
0‒1
0,0‒0,065
Лимфоциты
19‒37
1,2‒3,0
Моноциты
3‒11
0,09‒0,6
Число эозинофилов у взрослых людей в течение суток колеблется из-за непостоянного уровня кортикостероидов, гормонов, синтезируемых надпочечниками. Самый высокий показатель эозинофильных лейкоцитов определяется ночью, близко к утреннему времени, в течение дня же содержание Э-клеток в крови уменьшается.

У взрослых нормальный показатель – 500 эоз/мкл. Повышение данных до 5000 эоз/мкл, если оно стабильно держится в течение 2-3-х месяцев, свидетельствует о развитии гиперэозинофильного синдрома. Когда у взрослого повышаются одновременно с эозинофилами и базофилы, о чем это говорит? Только о развитии аллергической реакции в острой форме.
Лечение патологий, вызывающих повышение эозинофилов
Существует наследственная расположенность к повышенной концентрации эозинофилов. Она выявляется при обследовании всех членов семьи. При семейной эозинофилии показатели будут повышены одновременно у нескольких членов семьи, но следует отметить, что такая ситуация не вредит их здоровью. Для них нормальным является содержание эозинофилов в пределах 8-9%.

Повышаются нормы концентрации Э-клеток у взрослых на вредном производстве, если они работают с веществами, содержащими серу, или в резиновой промышленности. Наблюдается высокое содержание Э-клеток у наркоманов.
Но основной % заболеваний, вызывающих повышение эозинофилов, несет опасность здоровью:

При определении заболевания, вызвавшего повышение эозинофилов, врач назначает направленное лечение. Его задача – вылечить воспаление во внутренних органах, избавить человека от паразитов. На наличие глистной инвазии указывает одновременное повышение эозинофилов и моноцитов у взрослого, это говорит врачу о том, что требуется антипаразитарное лечение.

А вы знаете что такое эозинофилы?
Да
Что-то слышал (ла) о них
Нет
Проголосовать